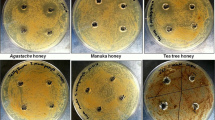

Abstract
Today, antibiotic therapies that previously worked well against certain bacteria due to their natural sensitivity, are becoming less effective. Honey has been proven to inhibit the biofilm formation of some respiratory bacteria, however few data are available on how the storage time affects the antibacterial effect. The activity of black locust, goldenrod, linden and sunflower honeys from three consecutive years (2020, 2021, 2022) was analyzed in 2022 against Gram-negative (Haemophilus influenzae, H. parainfluenzae, Pseudomonas aeruginosa) and Gram-positive (Streptococcus pneumoniae) bacteria using in vitro microbiological methods. After determining the physicochemical parameters of honey, broth microdilution was applied to determine the minimum inhibitory concentration of each honey type against each bacterium, and crystal violet assay was used to test their antibiofilm effect. The possible mechanism of action was explored with membrane degradation test, while structural changes were illustrated with scanning electron microscopy. Honeys stored for one or two years were darker than fresh honeys, while older honeys had significantly lower antibacterial activity. The most remarkable inhibitory effect was exerted by linden and sunflower honeys, and P. aeruginosa proved to be the most resistant bacterium. Based on our results, honey intended for medicinal purposes should be used as fresh as possible during a treatment.
Similar content being viewed by others
Introduction
Respiratory infections are extremely common, being one of the main causes of illness and death worldwide, and one of the most significant problems in clinical medicine. In the beginning, the symptoms are caused by viruses, and this is often followed by bacterial superinfection, primary bacterial infection develops only in a smaller proportion1. Regarding the resistance conditions of the most important upper respiratory tract pathogens, it can generally be said that macrolide and trimethoprim/sulfamethoxazole resistance is significant, and the number of penicillin-resistant or moderately sensitive bacterial strains is increasing. Antibiotic resistance can also occur in natural populations to a small extent, however, the clinical use and overuse of certain antibiotics exerts a strong selection pressure on the emergence of resistance2,3,4.
Bacterial communities colonize both the upper and lower respiratory tracts, but the highest bacterial density is found in the upper respiratory tract (URT). A characteristic of respiratory infections is that the causes of inflammation are actually members of the naturally present bacterial flora of the respiratory tract and primarily cause disease in an immunosuppressed state. Potentially infectious genera such as Streptococcus spp., Haemophilus spp., Pseudomonas spp. or Moraxella spp. can also be found in the microbiome of a healthy person5,6. These microbial communities often form biofilms, and mature biofilms show tolerance to environmental stressors, antibiotics and the body's immune responses. The bacterial biofilm provides optimal conditions and protection for the entire bacterial community7,8. The high degree of resistance can be attributed to the metabolic changes of the cells connected in the biofilm and the structural characteristics affecting the permeability of the drugs9. Extracellular polysaccharides (EPS), which play an important role in the formation of biofilms, can prevent the antibiotic from reaching the bacterial DNA, thereby providing a high degree of resistance to bacterial colonies10,11. Bacteria embedded in the polysaccharide matrix communicate with each other, the metabolism takes place through the channels of the matrix12. With the help of horizontal gene transfer, bacterial cells are able to transfer antibiotic resistance genes to each other, hence it is not necessary to develop resistance to a given agent from generation to generation13. In order to ensure the effectiveness of the treatment, it is definitely necessary to reduce the formation of biofilm or to destroy the biofilm, because 80% of bacterial infections are due to biofilm formation14.
Pseudomonas aeruginosa and Streptococcus pneumoniae, as well as Haemophilus species, are among the most frequently isolated respiratory bacteria capable of forming biofilms15. P. aeruginosa is a particularly dangerous Gram-negative opportunistic pathogenic bacterium, as most of its strains are antibiotic resistant16. The biofilm layer it creates reduces the surface area suitable for breathing in the lungs, thus creating optimal conditions for the reproduction of other microbes17. Two members of the Gram-negative Haemophilus genus, H. influenzae and H. parainfluenzae, are frequent colonizers of the respiratory system and can cause local and systemic infections and pose a serious threat to the human body. Due to the adhesion of biofilms, patients are exposed to increased risk, as antibiotic therapy is not successful in some cases18,19. In contrast to the pathogens mentioned so far, S. pneumoniae is a Gram-positive bacterium, and the symptoms of the disease are rather due to the inflammatory reactions than to the invasiveness of the microbe. It is a capsulated bacterium, which makes it easy to stick to the surface of the respiratory tract20. During pneumococcal infections, the bacterium adheres to the surface of the bronchi and creates a biofilm, thereby making the treatment of the infection more difficult. In many cases, biofilm structures can also be observed in certain areas of the lungs21,22. In light of these facts, and as a result of the large increase in antibiotic resistance, the use of natural agents and a more thorough knowledge of the microorganisms that cause diseases affecting the respiratory system become even more relevant23.
The antibiofilm effect of honey has been confirmed in several clinical studies, so its use as an additional therapy can be significant in the case of respiratory tract infections24. The glucose oxidase enzyme present in honey is secreted by the pharyngeal gland of the bee and its task is to convert glucose into gluconic acid δ-lactone, producing hydrogen peroxide as a by-product. The fact that the H2O2 content of honey is essential for its antibacterial activity has been supported by several research groups, with the maximum H2O2 concentration observed at honey dilutions between 15 and 50% (w/v)25, except for manuka honey, where H2O2 does not accumulate26. The hydrogen peroxide responsible for the bactericidal effect breaks down into water and oxygen over time, so its level decreases thanks to the plant-derived catalase enzyme. Based on these, it can be assumed that honeys stored for years lose their antibacterial effect due to the decrease in the activity of the enzyme glucose oxidase27,28. H2O2 can also be produced as a result of the prooxidant action of the biologically active polyphenols present in large quantities in honey. In this case, the pH value is an important parameter, it determines whether these compounds act as antioxidants or have an antibacterial effect29,30. However, low pH and high sugar content are often sufficient to inhibit microbial growth31.
During the antibiofilm activity, the active ingredients of honey diffuse into the biofilm matrix and, in addition to destroying the biofilm, prevent further biofilm formation by inhibiting adhesion processes32. Proano et al. observed that osmotic activity, H2O2 content, high sugar concentration and the presence of defensin-1 peptide are responsible for the hypertension in honey, and this condition leads to the suppression of biofilm formation33. H2O2 disrupts the attachment of bacterial cells and destabilizes the biofilm matrix, while bee-derived defensin-1 inhibits the formation of extracellular polymeric substances in addition to initial adhesion34,35. Polyphenolic components also prevent bacterial cells from connecting to each other or attaching to a given surface (biotic, abiotic), thus disrupting one of the most sensitive steps of biofilm formation. In addition to all this, polyphenolic compounds can inhibit the synthesis of EPS36. Sindi and his research team (2019) found that honey can reduce the number of viable bacterial cells within the mixed biofilm, and honey treatment also has a significant effect on metabolic activity37.
For the therapeutic use of honey, it is essential to ensure its quality. Honey can be contaminated with various microorganisms, including endospores of Clostridium botulinum and C. tetani. This fact is often overlooked, and in order to avoid a possible infection, it is important to sterilize honey intended for medicinal purposes38. In addition, nectar-producing plants are often sprayed with various herbicides and pesticides, compounds that also appear in honey. Environmental pollution, heavy metals from industrial areas, and antibiotic treatment of bees can also affect the quality of honey. Because of this, a clear definition of "medical grade honey" is definitely necessary to guarantee the safety and effectiveness of honeys during a treatment. Medical grade honey must fulfil the following criteria: “(1) organic, free of contaminants and toxic substances; (2) gamma-sterilized under standardized conditions, free of dangerous microorganisms; (3) can be safely implemented in medical therapies; (4) follows strict production and storage standards, legal and safety regulations; (5) complies to physicochemical criteria that are important for the use of honey as a wound care product”39.
The amount of catalase enzyme, the composition of the active ingredients and, in this context, the complex effect of different types of honeys can show significant differences depending on which species or region the honey comes from. The basic question of our research is to what extent storage time, and the botanical and geographical origin of four Hungarian varieties of honey (black locust, goldenrod, linden, sunflower) influence their antibacterial effect, and against which biofilm-forming bacterial strains is the antibacterial effect of each honey sample most effective. To our knowledge, no similar comparative study covering several years has been carried out yet for Hungarian varietal honeys.
Methods
Honey samples
For our tests, we used black locust/acacia (Robinia pseudo-acacia), goldenrod (Solidago gigantea), linden (Tilia spp.) and sunflower (Helianthus annuus) honeys purchased from the same Hungarian apiaries in three consecutive years (2020, 2021, 2022). The examination of the physicochemical parameters of honey and the testing of its antibacterial effect took place in 2022, not only in 2022 samples, but also in the case of samples from 2020 and 2021. The honey samples came from the southern Transdanubian region and were stored at room temperature (20–21 °C) and in the dark until used.
Melissopalynological analysis
In order to establish the true type of honeys, it is crucial to clarify their exact botanical origin, so we performed a melissopalynological analysis following the method of Von der Ohe et al.40. Ten grams of our honey samples were added to centrifuge tubes and mixed with 20 mL of distilled water using a Combi-spin FVL-2400N Vortex (Biocenter Kft., Szeged, Hungary). The subsequent centrifugation lasted for 10 min at a speed of 8753×g with a Neofuge 15R centrifuge (Lab-Ex Ltd., Budapest, Hungary), after which the supernatant was poured off. This step was followed by another centrifugation (5 min, 8753×g) and decantation, then 10 mL of distilled water was measured to the sediment left from the first centrifugation. In what follows, 250 μl of distilled water was added to the sediment remaining in the centrifuge tube, and after vortexing, 20 μl of the thus prepared pollen suspension was pipetted onto a microscope slide which was then placed on a heating plate set to 40 °C (OTS 40, Tiba Kft., Győr, Hungary). The water was evaporated, and then a small piece of Kaiser’s glycerin jelly with fuchsine (Merck Life Science Ltd., Budapest, Hungary) was added to each pollen sample. When the jelly melted, the preparations were covered with a coverslip. Pollen preparations were analyzed with Nikon Eclipse E200 microscope equipped with a Michrome 20MP CMOS digital camera (Auro-Science Consulting Kft., Budapest, Hungary), and photomicrographs were taken at 400 × magnification using 4.3.0.605 version of TCapture software41. At least 500 pollen grains were counted per honey sample, indicating how many pollen grains belong to a given plant species, genus or family. The relative frequency of pollen types was given as a percentage of all pollen grains.
Physicochemical parameters
The color intensity of the varietal honeys used in the tests was determined according to Beretta et al.42. The 50% (w/w) honey solutions prepared were placed in an ultrasonic water bath (water temperature: 45–50 °C) for 5 min and then filtered (0.45 µm pore size, Agilent Technologies, Milan, Italy). Color intensity results from the difference in absorbance values measured at 450 and 720 nm using a Shimadzu UV-1800 spectrophotometer (Shimadzu Schweiz GmbH, Reinach, Switzerland) were expressed in milliabsorbance units (mAU).
A DSZ-708 Multiparameter analyzer (Simex Ltd., Budapest, Hungary) was used to examine pH values and electrical conductivity. The pH value of the honey samples was determined according to the Codex Alimentarius and the pH meter was calibrated each time with buffer solutions at values of 4 and 943. For the measurement, 10 g of honey was dissolved in 75 ml of freshly distilled carbon dioxide-free water, and in the case of electrical conductivity, a 20% honey solution was prepared with distilled water. The electrical conductivity of honey means the conductivity of the honey solution measured at 20 °C, the results were expressed in milli-Siemens per centimeter (mS/cm)44.
Culture bacteria
The antibacterial effect of varietal honeys was investigated in case of both Gram-negative and Gram-positive bacteria. Haemophilus influenzae (DSM 4690) and H. parainfluenzae (DSM 8978) strains were grown in a supplemented Mueller Hinton broth special. 500 µl Haemophilus supplement B (Diagon Kft., Budapest, Hungary) and 750 µl (1 mg/ml) NAD were added to 3750 µl of Mueller–Hinton II Broth (MHB, Oxoid Ltd., London, UK). For Pseudomonas aeruginosa (ATCC 27853) and Streptococcus pneumoniae (DSM 20566), 100 ml of sterile MHB medium was used. The incubation time of bacterial suspensions was 12 h at 37 °C in a shaker incubator at 60 rpm (C25 Incubator Shaker, New Brunswick Scientific, Edison, NJ, USA)45. Before the tests, the bacteria were diluted to the given concentration with the appropriate medium.
Determination of minimum inhibitory concentrations (MIC) and minimum bactericidal concentration (MBC)
A broth microdilution test was used to determine the minimum inhibitory concentrations (MIC), which is commonly used in microbiological laboratories in accordance with CLSI guidelines (Clinical & Laboratory Standards Institute)46. The procedure was performed on 96-cell microtiter plates. Three dilution series were used, as we expected—based on preliminary experiments—that the antibacterial activity would decrease with increasing storage time. The following dilution series were prepared (using Mueller–Hinton broth): 42.5, 45, 47.5, 50, 52.5, 55, 57.5% (w/w) (2020 honeys), 25, 27.5, 30, 32.5, 35, 37.5, 40% (w/w) (2021 honeys) and 10, 12.5, 15, 17.5, 20, 22.5, 25% (w/w) (2022 honeys). Then 100 µL of the honey solutions and bacterial suspensions (105 CFU/mL) were measured into one cell of the microtiter plate, followed by incubation at 37 ℃ for 24 h. We performed our tests with six repetitions and considered the lowest honey concentration as the MIC, in which case there was no visible bacterial growth in the cells.
After the MIC determination, 10 µL of culture medium was taken from each cell of the microtiter plate, where no visible growth was observed, to test the minimum bactericidal concentration (MBC). In this case, the samples were cultured on BA plates and the incubation at 37 °C lasted for 24 h. Finally, we read the lowest concentration where no bacterial growth was observed on the plates47.
Biofilm inhibition study
The biofilms were formed on 96-cell microtiter plates applying the crystal violet (CV) assay, thereby testing the anti-biofilm effect of the honey samples48. The treatments were performed with honey samples with a concentration of MIC/2 and a bacterial suspension nutrient solution with a cell count of 108 CFU/mL was used as a positive control, and a cell-free honey nutrient solution was used as a negative control. As a first step, 200 μL of bacterial suspension was measured into one cell of the microtiter plate and the subsequent incubation at 37 °C lasted for four hours, thereby promoting the adhesion of the bacterial cells. The non-adherent cells were removed with physiological saline and only then were the honey solutions pipetted into the cells. In this case, the incubation was 24 h at 37 °C, and then the non-adherent cells were washed again with physiological saline. In order to fix the cells, 200 μL of methanol was added to each well for 15 min at room temperature (RT). In order to stain the bacterial biofilm, 200 μL of 0.1% crystal violet dye was applied after removing the methanol. After 20 min (RT), the excess dye was removed with water, and the crystal violet bound to the biofilm was dissolved with 200 μL of 33% acetic acid per cell. The absorbance values were determined at 590 nm using a plate reader (BMG Labtech SPECTROstar Nano, Budapest, Hungary). Among other things, the crystal violet dye binds to extracellular polysaccharides (EPS) which play an important role in the formation of biofilms, therefore enabling the estimation of the total biomass of the biofilm in the cell of the microtiter plate. The inhibition rate was determined based on the following formula: (1 − S/C) × 100% (C and S were defined as the average absorbance of control and sample groups, respectively)49.
Membrane degradation assay
During the study of cell material release, each bacterial suspension (108 CFU/mL) was prepared in PBS (phosphate buffer saline) and bacterial cells without honey treatment were used as a control. The bacterial cells were treated with honey samples of 20, 40 and 60% (w/w) concentration for one hour. In addition, the time dependence of membrane degradation was also investigated, in this test the bacterial cells were suspended in PBS containing 60% (w/w) honey. The treatments lasted: 0, 10, 20, 40, 60 and 90 min. After the treatments, the bacterial cells were centrifuged in both cases (Neofuge 15R, Lab-Ex Ltd., Budapest, Hungary) at 12,000×g for 2 min. The absorbance of the supernatant containing nucleic acid was measured at 260 nm with a Metertech SP-8001 (Abl&e-Jasco Ltd., Budapest, Hungary) spectrophotometer. The results were expressed as a percentage, compared to the control50.
Scanning electron microscopy (SEM)
In order to visualize the inhibitory effect of honey on biofilm and to illustrate the structural changes, SEM images were taken. Both Gram-positive (S. pneumoniae) and Gram-negative (P. aeruginosa) bacteria were included in the study, and the samples were treated with linden honey which has an effective antibiofilm effect.
During the procedure, biofilms were formed on degreased and sterilized coverslips after the plates were incubated for 4 h at 37 °C in 5 mL of bacterial suspension (105 CFU/mL). After the adhesion, washing with physiological saline followed, and then linden honey from three different years was applied at a concentration of MIC/2 (5 mL). Untreated coverslips were used as controls. After 24 h of incubation (37 °C), non-adherent cells were washed again, and this was followed by 2 h (RT) incubation in 2.5% glutaraldehyde to fix the biofilm. The samples were dehydrated in absolute ethanol (50%, 70%, 80% and 90% solutions) for 2 × 15 min (RT). As a next step, the coverslips were placed in a 1:2, 1:1, 2:1 mixture of t-butyl alcohol and absolute ethanol. The samples were then transferred to absolute t-butyl alcohol for 1–1 h (RT) followed by overnight freeze-drying. The examination of biofilms coated with a gold membrane was performed with a JEOL JSM IT500-HR scanning electron microscope (Jeol Ltd., Tokyo, Japan)51.
Statistical analysis
Statistical analyses were carried out using Excel® (Microsoft Corp., Redmond, WA, USA) and the PAST software package version 3.1152 after normality checking with the Shapiro–Wilk test. Data were expressed as means ± standard deviations (SD) in case of honey type absorbance (Table 2) and membrane degradation results (Tables 5, 6). Results of antibiofilm activity (Fig. 1) were expressed as median (minimum to maximum) in box plots. The honey types had been compared with each other based on a given parameter using one-way ANOVA. If the null hypothesis of the ANOVA was rejected, we used Student t-test to establish a difference between the two group pairs (honey types). The p-values at 1% (p ≤ 0.01) or 5% (p ≤ 0.05) were considered significant.
Biofilm inhibitory rates of honey samples against H. influenzae (A), H. parainfluenzae (B), P. aeruginosa (C) S. pneumoniae (D). Bl-black locust honey, L-linden honey, S-sunflower honey, G-goldenrod honey. Data are expressed using box plots, minimum to maximum values are presented by vertical lines, while median within the plot as horizontal line. Lowercase letters above the boxes indicate significant differences between the means of inhibitory rates, the same lowercase letters above the boxes indicate mean values that are not significantly different from each other; different lowercase letters indicate means, which are significantly different (p ≤ 0.01).
Results
Melissopalynological analysis and Physicochemical parameters of honey samples
Based on the pollen analysis and examination of the physicochemical properties of the honeys included in the research, all honey samples can be considered unequivocally as varietal honey (Tables 1 and 2). In black locust honeys, R. pseudoacacia pollen was the dominant pollen type in accordance with the honey type declared by the beekeeper, similarly to goldenrod, linden and sunflower honeys which also contained high amounts of Solidago, Tilia and Helianthus pollen, respectively.
The color of honey is one of the most variable parameters, which can range from white, through pale yellow and red, to black. In this case, the determining factor is the plant origin and the storage time. The color of fresh black locust honey was pale, yellowish green, but the stored samples were darker (44.4 ± 1.7 vs. 103.1 ± 3.0 mAU), approaching the color of light amber colored linden honey. We observed a similar color change in the case of the other honey samples. The most obvious contrast between fresh and stored honey colors was experienced in sunflower honeys (116.6 ± 1.5 vs. 422.8 ± 2.0 mAU). The highest difference in color intensity was measured between honey samples stored for two vs. one year, afterwards we did not observe any significant difference in smell and texture in the next 2 years.
The pH of honey mainly depends on dissociated acids, which affects both the development of microorganisms and enzyme activity. The pH value of the varietal honeys varied between 3.22 and 4.32. Regarding the average of 3 years, the highest values were measured in linden honeys (4.26 ± 0.07), the lowest values in black locust honeys (3.26 ± 0.04). Also electrical conductivity was the lowest in black locust honey (0.126 ± 0.01 mS/cm), followed by sunflower (0.222 ± 0.002 mS/cm), linden (0.589 ± 0.02 mS/cm) and goldenrod honey (0.616 ± 7.2 mS/cm). The pH and electrical conductivity did not change with storage time, so similar values were obtained for honeys of the same variety from different years.
MIC and MBC determination
The MIC and MBC values of the investigated honey samples showed variation in terms of the storage time, the type of honey, and the bacterial strains included in the study (Tables 3 and 4). Based on our results, it can be observed that as the storage time increased, higher concentrations of honey solutions were needed to achieve the appropriate inhibitory effect. In the case of the 2020 honeys, the MIC values ranged between 42.5 and 50%, while for the 2022 samples, between 10 and 17.5%. A difference of a similar magnitude was also experienced for the MBC values.
Linden and sunflower honey exerted the most significant inhibitory effect, while black locust honey was the least active. Haemophilus strains were the most sensitive, while P. aeruginosa proved to be the most resistant bacterium.
Antibiofilm activity
When examining the inhibitory effect of honey on biofilm formation, the individual honeys were used at a concentration of MIC/2. It is clearly visible also in this series of tests that the antibacterial activity of stored honeys is lower than that of fresh honeys (Fig. 1). When measured in 2022, the average inhibition rate of 2020 honeys (34.7–53.4%) was about half of that of 2022 honeys (67.9–83.2%). The 2021 samples inhibited biofilm formation by 45.3–66.8%. The antibiofilm effect of linden and sunflower honey was the most remarkable, the inhibition rate for the 2022 samples reached 80% against Haemophilus strains. Black locust and goldenrod honeys showed lower activity, but the fresh samples from 2022 also inhibited biofilm formation by an average of 70% in the selected bacterial strains. Considering each sampling year, the honey samples were able to exert the most significant antibiofilm effect against Haemophilus strains, while their activity was lower in the case of P. aeruginosa and S. pneumoniae strains.
Membrane degradation
To demonstrate one of the mechanisms of action of honey, we chose linden honey, which showed high activity in previous studies. In this series of experiments, we also worked with samples from three consecutive years and studied the membrane-degrading effect of honey solutions of different concentrations (20, 40, 60, 90%) in the case of Gram-negative (P. aeruginosa) and Gram-positive (S. pneumoniae) bacteria (Table 5). In the 2020 linden honey treatment, the loss of integrity of the bacterial membrane was observed at concentrations of 60% and above, while when the 2021 sample was used, membrane degradation occurred already at a concentration of 40%. The highest release of cell material was measured when 2022 linden honey was used, here some activity occurred even at the low concentration of 20%. Using the 2022, 60% honey treatment, the proportion of lysed cells for the S. pneumoniae bacterium reached 43.7%.
In order to investigate the kinetics of cell material release, the 60% solution of the samples was measured at different time intervals (20, 40, 60, 90 min). This experiment showed how many minutes it took for the bacterial membrane to start breaking down after the treatment with linden honey from different years (Table 6). The release of DNA from the bacterial cells started at 20 and 60 min in case of 2022 and 2020 linden honey, respectively. Based on our results, Gram-negative P. aeruginosa proved to be a more resistant bacterium in this case as well (Tables 5 and 6).
Scanning electron microscopy (SEM)
The inhibitory effect of highly active linden honey on the biofilm formation of Gram-negative (P. aeruginosa) and Gram-positive (S. pneumoniae) bacteria was illustrated in SEM images (Fig. 2). In the case of untreated samples, the three-dimensional structure of bacterial biofilms was formed (Fig. 2A,E), while in the case of treated samples, biofilm formation was inhibited to an extent corresponding to the age of the honeys. The 2020 and 2021 linden honey reduced biofilm formation to a lesser extent (Fig. 2B,C,F,G) than the 2022 (Fig. 2D,H), similar to previous results. S. pneumoniae bacterial cells treated with 2022 linden honey were crushed and their cell material burst out (Fig. 2H). In addition, it can be observed in the images of the untreated samples that P. aeruginosa produces a larger amount of biofilm than S. pneumoniae during the same time, thus contributing to the increase of its resistance (Fig. 2A,E).
Discussion
Prior to our current research, we had already demonstrated the antibiofilm effect of several Hungarian varieties of honey against bacterial strains that cause respiratory and wound infections53,54, however, no studies have yet been conducted to determine the extent to which honeys stored for several years lose from their antibacterial activity. We once again included respiratory biofilm-forming bacteria in our series of experiments, as there are still few data available on the reaction of these bacteria after treatment with honey, and respiratory diseases of bacterial origin are a serious problem worldwide. Our research work, which has been going on for several years, helps us to get to know these bacteria more thoroughly, as well as to develop alternative complementary therapies that could reduce the risk of developing antibiotic resistance. In the present study, we demonstrated for the first time how the antibiofilm effect of stored vs. fresh honey samples changes in case of four different types of Hungarian honeys against both Gram-positive and Gram-negative respiratory bacteria. In addition, we were able to gain insight into the kinetics and possible mechanism of the antibacterial effect with the help of membrane degradation tests. As a limitation of our study, it has to be noted that not the same honey samples were studied in three consecutive years, but the same honey type harvested in the same geographical region in three consecutive years, with highly similar pollen profile each year.
Based on the examination of the physicochemical parameters of the samples, the electrical conductivity, which is closely related to the pH and macro- and microelement content, proved to be constant over the years, and several research groups measured values similar to our results55,56,57,58. However, the color intensity of stored honeys was higher, reflecting their darker color compared to fresh honeys. Brudzynski and Kim59 measured a lower degree of color change for lighter honeys (e.g. borage) than for darker honeys (e.g. sunflower). We also observed a significant difference in the color of stored vs. fresh sunflower honey, but the difference was also relevant for the lighter black locust honey. The change was not so remarkable in the lighter linden honey and the darker goldenrod honey, so it is assumed that the type of honey and not the starting color of the honey is the decisive factor in the degree of change in color intensity.
Several research groups found that the antibacterial effect of most types of honey is largely dependent on the H2O2 content60,61, but low pH, high sugar content (osmolarity), and the presence of antimicrobial proteins/peptides also all contribute to the antibacterial activity of the honey31,62. In general, the higher the hydrogen peroxide and total polyphenol content of a given honey is, the more significant its bacteriostatic and bactericidal effects are60. The advantage of the non-peroxide antibacterial effect is that it remains intact even after a longer storage time63, while H2O2 degrades over time thanks to the catalase enzyme28. From this, we can conclude that H2O2 plays a key role in the process of changing activity, since the ratio of the other components responsible for antibacterial activity (non-peroxides) does not change to such an extent over the years63. However, high heat and light exposure can also contribute to the degradation of biologically active polyphenols64.
Our research has proven that even honeys stored for one year display lower levels of antibacterial effect, and in the case of two-year-old samples, lower activity was even more pronounced. The antibiofilm activity of the 2021 honey samples was lower by an average of 20–25%, however, the inhibition ratio of the linden honeys was over 60% against all bacterial strains even after one year. Our results suggest that the strong antibacterial effect of linden honey is partially attributable to the non-peroxide factor(s), as reported by Farkasovska et al.61. Compared to the 2022 harvest, the antibiofilm effect of the 2020 honeys was almost halved. During the study of buckwheat honeys, Brudzynski and Kim59 determined that the MIC value of honeys decreased by 50% in the first 3–6 months of storage, while the further decrease in antibacterial activity took place gradually against Bacillus subtilis and Escherichia coli bacteria. In our series of experiments, after one year, a 50–60% decrease in activity was observed in terms of the MIC values for each type of honey for all tested bacterial strains. The MIC values of the most active linden and sunflower honeys were 12.5% vs. 32.5% against the most resistant P. aeruginosa bacterium in 2022 vs. 2021, respectively.
Farkasovska et al.61 studied acacia, linden, rapeseed, sunflower and multifloral honey from Slovakia and found that in most honey samples H2O2 content correlated with their antibacterial activity, expressed as MIC. Similarly to our findings, sunflower and linden honeys exhibited the strongest antibacterial effect. While the H2O2 content of sunflower honeys showed correlation with their MIC values; linden honeys were exceptional in terms of antibacterial activity, which showed weak or no correlation with H2O2 content, depending on the bacterial strains. The outstanding inhibitory effect of linden honey has already been described in several studies, and factors other than H2O2 content were suggested as potential inhibitors of bacteria53,61,65,66,67. Few data are available regarding the level of antibacterial activity of sunflower honey, in this case the variety and geographical origin of the floral source may be an important influencing factor. Of the three Serbian honey samples studied by Đurović et al.68, sunflower honey had the second strongest antibacterial effect, which was higher than that of acacia honey, but lower than that of forest-meadow honey, with a MIC value of 12.5% against Staphylococcus aureus or Serratia marcescens bacteria. We also obtained similar results, the MIC value for P. aeruginosa was 12.5%, while for the other bacteria it was 10%. In accordance with the data published in our previous study, all Hungarian varieties of honey had an antibiofilm and bacteriostatic effect, but black locust honey and goldenrod honey showed less relevant inhibition53,54.
Similar to what was observed in our previous series of membrane degradation experiments53, the amount of DNA released from bacterial cells was more significant for Gram-positive S. pneumoniae than for Gram-negative P. aeruginosa bacteria after linden honey treatment. The studies of Otmani et al.69 also support the fact that Gram-positive bacteria are less resistant to honey treatments due to their structure. However, several studies have been published in which Gram-negative bacteria proved to be more sensitive68,70, including one of our previous studies54, which supports this, where we used bacterial strains that cause wound infection. Although the outer membrane of these bacteria may provide greater protection, the destruction of the lipopolysaccharide layer increases the permeability of the outer membrane, which can greatly contribute to release of the genetic material of the bacterial cell71. These different results show that the structure of the bacteria may play a smaller role in the development of resistance, rather the specific defense mechanisms of each strain are decisive. In our series of tests, we were the first to explore which concentration of linden honey is required for the degradation of the bacterial membrane, depending on the storage time. To date no other study has examined the effect of varietal honeys on the bacterial membrane as a function of storage time.
Conclusions
Honey has a strong antibacterial effect, however, in order for it to be an additional therapy to an antibiotic course, several aspects must be taken into account. Our study highlights the importance of the botanical origin of honey, as some types of honey can exert a more significant inhibitory effect, and it is also relevant that the treatment should be applied against the bacterial strains that are the most sensitive to the given honey type. In addition, our research also answered the question of how much the age of honey can influence its antibacterial effect, and to what extent the antibiofilm activity decreases depending on the storage time. Our research group was the first to investigate the antibiofilm effect of honey samples stored for different time periods, as well as one of the mechanisms behind this, bacterial membrane degradation and its kinetics. Based on our results, honeys suitable for medicinal purposes should be used as fresh as possible during the various treatments, since in this case they exert the most significant antibacterial activity.
Data availability
The datasets generated during and/or analysed during the current study are available from the corresponding author on reasonable request.
References
Paul, J. Respiratory Tract Infections. Disease Causing Microbes 99–148 (Springer, 2024). https://doi.org/10.1007/978-3-031-28567-7_3.
Palumbi, S. R. Humans as the world’s greatest evolutionary force. Science. 293, 1786–1790. https://doi.org/10.1126/science.293.5536.1786 (2001).
Levy, S. B. & Marshall, B. Antibacterial resistance worldwide: Causes, challenges and responses. Nat. Med. 10, 122–129. https://doi.org/10.1038/nm1145 (2004).
Clatworthy, A. E., Pierson, E. & Hung, D. T. Targeting virulence: A new paradigm for antimicrobial therapy. Nat. Chem. Biol. 3, 541–548. https://doi.org/10.1038/nchembio.2007.24 (2007).
Man, W. H., de SteenhuijsenPiters, W. A. A. & Bogaert, D. The microbiota of the respiratory tract: Gatekeeper to respiratory health. Nat. Rev. Microbiol. 15, 259–270. https://doi.org/10.1038/nrmicro.2017.14 (2017).
Paramasivan, S. et al. The international sinonasal microbiome study: A multicentre, multinational characterization of sinonasal bacterial ecology. Allergy. 75, 2037–2049. https://doi.org/10.1111/all.14276 (2020).
Hall-Stoodley, L. et al. Towards diagnostic guidelines for biofilm-associated infections. FEMS. Immunol. Med. Microbiol. 65, 127–145. https://doi.org/10.1111/j.1574-695X.2012.00968.x (2012).
Vestby, L. K., Grønseth, T., Simm, R. & Nesse, L. L. Bacterial biofilm and its role in the pathogenesis of disease. Antibiotics. 9, 59. https://doi.org/10.3390/antibiotics9020059 (2020).
Jolivet-Gougeon, A. & Bonnaure-Mallet, M. Biofilms as a mechanism of bacterial resistance. Drug Discov. Today Technol. 11, 49–56. https://doi.org/10.1016/j.ddtec.2014.02.003 (2014).
Costerton, J. W., Stewart, P. S. & Greenberg, E. P. Bacterial biofilms: A common cause of persistant infections. Science. 284, 1318–1322. https://doi.org/10.1126/science.284.5418.1318 (1999).
Taraszkiewicz, A., Fila, G., Grinholc, M. & Nakonieczna, J. Innovative strategies to overcome biofilm resistance. BioMed. Res. Int. 13, 150–653. https://doi.org/10.1155/2013/150653 (2013).
Wilking, J. N. et al. Liquid transport facilitated by channels in Bacillus subtilis biofilms. Proc. Natl. Acad. Sci. USA. 110, 848–852. https://doi.org/10.1073/pnas.1216376110 (2013).
Kasuya, M. Transfer of drug resistance between enteric bacteria inducedin the mouse intestine. J. Bacteriol. 88, 322–328. https://doi.org/10.1128/jb.88.2.322-328.1964 (1964).
Wang, Y. et al. Effects of quorum sensing autoinducer degradation gene on virulence and biofilm formation of Pseudomonas aeruginosa. Sci. China C. Life Sci. 50, 385–391. https://doi.org/10.1007/s11427-007-0044-y (2007).
Welp, A. L. & Bomberger, J. M. Bacterial community interactions during chronic respiratory disease. Front. Cell. Infect. Microbiol. 10, 213. https://doi.org/10.3389/fcimb.2020.00213 (2020).
Todar, K. Online Textbook of Bacteriology. https://www.textbookofbacteriology.net/ (2008).
Steindler, L. et al. LasI/R and RhlI/R quorum sensing in a strain of Pseudomonas aeruginosa beneficial to plants. Appl. Environ. Microbiol. 75, 5131–5140. https://doi.org/10.1128/AEM.02914-08 (2009).
Mohd-Zain, Z., Kamsani, N. H., Ismail, I. S. & Ahmad, N. Antibiotic susceptibility profile of Haemophilus influenzae and transfer of co-trimoxazole resistance determinants. Trop. Biomed. 29, 372–380 (2012).
Wen, S., Feng, D., Chen, D., Yang, L. & Xu, Z. Molecular epidemiology and evolution of Haemophilus influenzae. Infect. Genet. Evol. 80, 1–6. https://doi.org/10.1016/j.meegid.2020.104205 (2020).
Suaya, J. A. et al. Identification of Streptococcus pneumoniae in hospital-acquired pneumonia in adults: A systematic review. J. Hosp. Infect. 108, 146–157. https://doi.org/10.1016/j.jhin.2020.09.036 (2020).
Sanchez, C. J. et al. The pneumococcal serine-rich repeat protein is an intra-species bacterial adhesin that promotes bacterial aggregation in vivo and in biofilms. PLoS Pathog. 6, e1001044. https://doi.org/10.1371/journal.ppat.1001044 (2010).
Domenech, M., García, E. & Moscoso, M. Biofilm formation in Streptococcus pneumoniae. Microb. Biotechnol. 5, 455–465. https://doi.org/10.1111/j.1751-7915.2011.00294.x (2012).
Ruopp, M., Chiswell, K., Thaden, J. T., Merchant, K. & Tsalik, E. L. Respiratory tract infection clinical trials from 2007 to 2012: A systematic review of ClinicalTrials.gov. Ann. Am. Thorac. Soc. 12, 1852–1863. https://doi.org/10.1513/AnnalsATS.201505-291OC (2015).
Krishnakumar, G. S., Mahendiran, B., Gopalakrishnan, S., Muthusamy, S. & Elangovan, S. M. Honey based treatment strategies for infected wounds and burns: A systematic review of recent pre-clinical research. Wound Med. 30, 100188. https://doi.org/10.1016/j.wndm.2020.100188 (2020).
Brudzynski, K. A current perspective on hydrogen peroxide production in honey: A review. Food Chem. 332, 127229. https://doi.org/10.1016/j.foodchem.2020.127229 (2020).
Majtan, J., Bohova, J., Prochazka, E. & Klaudiny, J. Methylglyoxal may affect hydrogen peroxide accumulation in manuka honey through the inhibition of glucose oxidase. J. Med. Food. 17, 290–293. https://doi.org/10.1089/jmf.2012.0201 (2014).
Dustmann, J. H. Antibacterial effect of honey. Apiacta. 14, 7–11 (1979).
Bucekova, M. et al. Microwave processing of honey negatively affects honey antibacterial activity by inactivation of bee-derived glucose oxidase and defensin-1. Food Chem. 240, 1131–1136. https://doi.org/10.1016/j.foodchem.2017.08.054 (2018).
de Graft-Johnson, J. & Nowak, D. Effect of selected plant phenolics on Fe2+-EDTA-H2O2 system mediated deoxyribose oxidation: Molecular structure-derived relationships of anti- and pro-oxidant actions. Molecules. 22, 59. https://doi.org/10.3390/molecules22010059 (2017).
Liu, X. et al. Green tea polyphenols function as prooxidants to inhibit Pseudomonas aeruginosa and induce the expression of oxidative stress-related genes. Folia Microbiol. 58, 211–217. https://doi.org/10.1007/s12223-012-0198-2 (2013).
Mandal, D. M. & Mandal, S. Honey: Its medicinal property and antibacterial activity. Asian Pac. J. Trop. Biomed. 1, 154–160. https://doi.org/10.1016/S2221-1691(11)60016-6 (2011).
Khataybeh, B., Jaradat, Z. & Ababneh, Q. Anti-bacterial, anti-biofilm and anti-quorum sensing activities of honey: A review. J Ethnopharmacol. 317, 116830. https://doi.org/10.1016/j.jep.2023.116830 (2023).
Proano, A. et al. The osmotic action of sugar combined with hydrogen peroxide and bee-derived antibacterial peptide Defensin-1 is crucial for the antibiofilm activity of eucalyptus honey. LWT-Food Sci. Technol. 136, 110379. https://doi.org/10.1016/j.lwt.2020.110379 (2021).
Santiago, A. J. et al. Inhibition and dispersal of Pseudomonas aeruginosa biofilms by combination treatment with escapin intermediate products and hydrogen peroxide. Antimicrob. Agents Chemother. 60(9), 5554–5562. https://doi.org/10.1128/aac.02984-15 (2016).
Sojka, M., Valachova, I., Bucekova, M. & Majtan, J. Antibiofilm efficacy of honey and bee-derived defensin-1 on multispecies wound biofilm. J. Med. Microbiol. 65(4), 337–344. https://doi.org/10.1099/jmm.0.000227 (2016).
Zamuz, S. et al. The role of phenolic compounds against Listeria monocytogenes in food: A review. Trends Food Sci. Technol. 110, 385–392. https://doi.org/10.1016/j.tifs.2021.01.068 (2021).
Sindi, A. et al. Anti-biofilm effects and characterisation of the hydrogen peroxide activity of a range of Western Australian honeys compared to Manuka and multifloral honeys. Sci. Rep. 9(1), 1–17. https://doi.org/10.1038/s41598-019-54217-8 (2019).
Chou, J. W., Skornicki, M. & Cohen, J. T. Unintended consequences of the potential phase-out of gamma irradiation. F1000 Res. 7, 348. https://doi.org/10.12688/f1000research.14090.1 (2018).
Hermanns, R. et al. Defining the standards for medical grade honey. J. Apicult. Res. https://doi.org/10.1080/00218839.2019.1693713 (2019).
Von Der Ohe, W., Oddo, L. P., Piana, M. L., Morlot, M. & Martin, P. Harmonized methods of melissopalynology. Apidologie. 35, S18–S25. https://doi.org/10.1051/apido:2004050 (2004).
TCapture V4.3.0.605 (2022). https://www.tucsen.com/uploads/TCapture4.3.0.605.zip.
Beretta, G., Granata, P., Ferrero, M., Orioli, M. & Facino, R. M. Standardization of antioxidant properties of honey by a combination of spectrophotometric/fluorimetric assays and chemometrics. Anal. Chim. Acta. 533, 185–191. https://doi.org/10.1016/j.aca.2004.11.010 (2005).
Codex Alimentarius. Revised Codex Standard for Honey. Codex STAN 12–1981, Rev. 1 (1987), Rev. 2. (2001).
Bogdanov, S. et al. Harmonised methods of the European honey commission. Apidol. Extra Issue. 1, 1–59 (1997).
Hindler, J. A. & Jorgensen, J. H. Susceptibility test methods: Fastidious bacteria. In Manual of Clinical Microbiology (ed. Versalovic, J.) 1180–1187 (ASM, 2011).
CLSI. Methods for Dilution Antimicrobial Susceptibility Tests for Bacteria That Grow Aerobically; Approved Standard—Ninth Edition, CLSI Document M07-A9. (Clinical and Laboratory Standards Institute, 2012).
Tan, H. T. et al. The antibacterial properties of Malaysian tualang honey against wound and enteric microorganisms in comparison to manuka honey. BMC Complement. Altern. Med. 9, 34. https://doi.org/10.1186/1472-6882-9-34 (2009).
Peeters, E., Nelis, H. J. & Coenye, T. Comparison of multiple methods for quantification of microbial biofilms grown in microtiter plates. J. Microbiol. Methods. 72, 157–165. https://doi.org/10.1016/j.mimet.2007.11.010 (2008).
Yanwei, S. et al. Effect of sub-minimum inhibitory concentrations of lemon essential oil on the acid tolerance and biofilm formation of Streptococcus mutans. Arch. Oral. Biol. 87, 235–241. https://doi.org/10.1016/j.archoralbio.2017.12.028 (2018).
Bennis, S., Chami, F., Chami, N., Bouchikhi, T. & Remmal, A. Surface alteration of Saccharomyces cerevisiae induced by thymol and eugenol. Lett. Appl. Microbiol. 38, 454–458. https://doi.org/10.1111/j.1472-765X.2004.01511.x (2004).
Kerekes, E.-B. et al. Anti-biofilm forming and anti-quorum sensing activity of selected essential oils and their main components on food-related micro-organisms. J. Appl. Microbiol. 115, 933–942. https://doi.org/10.1111/jam.12289 (2013).
Hammer, Ø., Harper, D. A. & Ryan, P. D. PAST: Paleontological statistics software package for education and data analysis. Palaeontol. Electron. 4, 9 (2001).
Balázs, V. L. et al. In vitro antibacterial and antibiofilm activity of Hungarian honeys against respiratory tract bacteria. Foods. 10, 1632. https://doi.org/10.3390/foods10071632 (2021).
Balázs, V. L. et al. Antibacterial and antibiofilm effect of Unifloral honeys against bacteria isolated from chronic wound infections. Microorganisms. 11, 509. https://doi.org/10.3390/microorganisms11020509 (2023).
Majewska, E., Drużyńska, B. & Wołosiak, R. Determination of the botanical origin of honeybee honeys based on the analysis of their selected physicochemical parameters coupled with chemometric assays. Food Sci. Biotechnol. 28, 1307–1314. https://doi.org/10.1007/s10068-019-00598-5 (2019).
Bodor, Z. et al. Sensory and physicochemical evaluation of acacia and linden honey adulterated with sugar syrup. Sensors 20, 4845. https://doi.org/10.3390/s20174845 (2020).
Pauliuc, D., Oroian, M. & Ciursă, P. Organic acids content, sugars content and physicochemical parameters of Romanian acacia honey. Ukr. Food J. 10, 1. https://doi.org/10.24263/2304-974X-2021-10-1-14 (2021).
Dżugan, M. et al. SDS-PAGE protein and HPTLC polyphenols profiling as a promising tool for authentication of goldenrod honey. Foods. 11, 2390. https://doi.org/10.3390/foods11162390 (2022).
Brudzynski, K. & Kim, L. H. Storage-induced chemical changes in active components of honey de-regulate its antibacterial activity. Food Chem. 126, 1155–1163. https://doi.org/10.1016/j.foodchem.2010.11.151 (2011).
Bucekova, M. et al. Antibacterial activity of different blossom honeys: New findings. Molecules. 24, 1573. https://doi.org/10.3390/molecules24081573 (2019).
Farkasovska, J., Bugarova, V., Godocikova, J., Majtan, V. & Majtan, J. The role of hydrogen peroxide in the antibacterial activity of different floral honeys. Eur. Food Res. Technol. 245, 2739–2744. https://doi.org/10.1007/s00217-019-03393-y (2019).
Nolan, V. C., Harrison, J. & Cox, J. A. Dissecting the antimicrobial composition of honey. Antibiotics. 8, 251. https://doi.org/10.3390/antibiotics8040251 (2019).
Libonatti, C., Varela, S. & Basualdo, M. Antibacterial activity of honey: A review of honey around the world. J. Microbiol. Antimicrob. 6, 51–56. https://doi.org/10.5897/JMA2014.0308 (2014).
Barnes, J. S., Foss, F. W. & Schug, K. A. Thermally accelerated oxidative degradation of quercetin using continuous flow kinetic electrospray-ion trap-time of flight mass spectrometry. J. Am. Soc. Mass Spectrom. 24, 1513–1522. https://doi.org/10.1007/s13361-013-0698-6 (2013).
Matzen, R. D. et al. The antibacterial effect in vitro of honey derived from various Danish flora. Dermatol. Res. Pract. 2018, 7021713. https://doi.org/10.1155/2018/7021713 (2018).
Farkas, Á. et al. Antibacterial and biofilm degradation effects of Hungarian honeys linked with botanical origin, antioxidant capacity and mineral content. Front. Nutr. 9, 953470. https://doi.org/10.3389/fnut.2022.953470 (2022).
Sakac, M. et al. Antioxidative, antibacterial and antiproliferative properties of honey types from the Western Balkans. Antioxidants. 11, 1120. https://doi.org/10.3390/antiox11061120 (2022).
Đurovic, V. et al. Comparative analysis of antibacterial and antioxidant activity of three different types of honey. Acta Agric. Serb. 27, 115–120. https://doi.org/10.5937/AASer2254115D (2022).
Otmani, A. et al. Phenolic compounds and antioxidant and antibacterial activities of Algerian honeys. Food Biosci. 42, 101070. https://doi.org/10.1016/j.fbio.2021.101070 (2021).
Combarros-Fuertes, P. et al. Antibacterial action mechanisms of honey: Physiological effects of avocado, chestnut, and polyfloral honey upon Staphylococcus aureus and Escherichia coli. Molecules 25, 1252. https://doi.org/10.3390/molecules25051252 (2020).
Brudzynski, K. & Sjaarda, C. Antibacterial compounds of Canadian honeys target bacterial cell wall inducing phenotype changes, growth inhibition and cell lysis that resemble action of β-lactam antibiotics. PLoS ONE. 9, e106967. https://doi.org/10.1371/journal.pone.0106967 (2014).
Acknowledgements
This work was supported by a grant from the National Research, Development and Innovation Office; NKFIH K 132044, by János László Research Grant and by Ildikó Kriszbacher Talent Grant.
Funding
Open access funding provided by University of Pécs.
Author information
Authors and Affiliations
Contributions
L.N.-R. conceived and designed the study and edited the manuscript. L.N.-R. and V.L.B. performed microbiological studies. L.N.-R., Á.F. and M.K. wrote the draft of the paper. L.N.-R. and M.K. performed statistical analysis and generated figures and tables. L.N.-R., V.L.B. and P.Sz. carried out SEM studies. B.K., V.D.Á., V.B. and E.Cs. helped with the microbiological experiments. All authors have read and revised the manuscript.
Corresponding author
Ethics declarations
Competing interests
The authors declare no competing interests.
Additional information
Publisher's note
Springer Nature remains neutral with regard to jurisdictional claims in published maps and institutional affiliations.
Rights and permissions
Open Access This article is licensed under a Creative Commons Attribution 4.0 International License, which permits use, sharing, adaptation, distribution and reproduction in any medium or format, as long as you give appropriate credit to the original author(s) and the source, provide a link to the Creative Commons licence, and indicate if changes were made. The images or other third party material in this article are included in the article's Creative Commons licence, unless indicated otherwise in a credit line to the material. If material is not included in the article's Creative Commons licence and your intended use is not permitted by statutory regulation or exceeds the permitted use, you will need to obtain permission directly from the copyright holder. To view a copy of this licence, visit http://creativecommons.org/licenses/by/4.0/.
About this article
Cite this article
Nagy-Radványi, L., Balázs, V.L., Kocsis, B. et al. Antibacterial activity of Hungarian varietal honeys against respiratory pathogens as a function of storage time. Sci Rep 14, 10200 (2024). https://doi.org/10.1038/s41598-024-60961-3
Received:
Accepted:
Published:
DOI: https://doi.org/10.1038/s41598-024-60961-3
Comments
By submitting a comment you agree to abide by our Terms and Community Guidelines. If you find something abusive or that does not comply with our terms or guidelines please flag it as inappropriate.